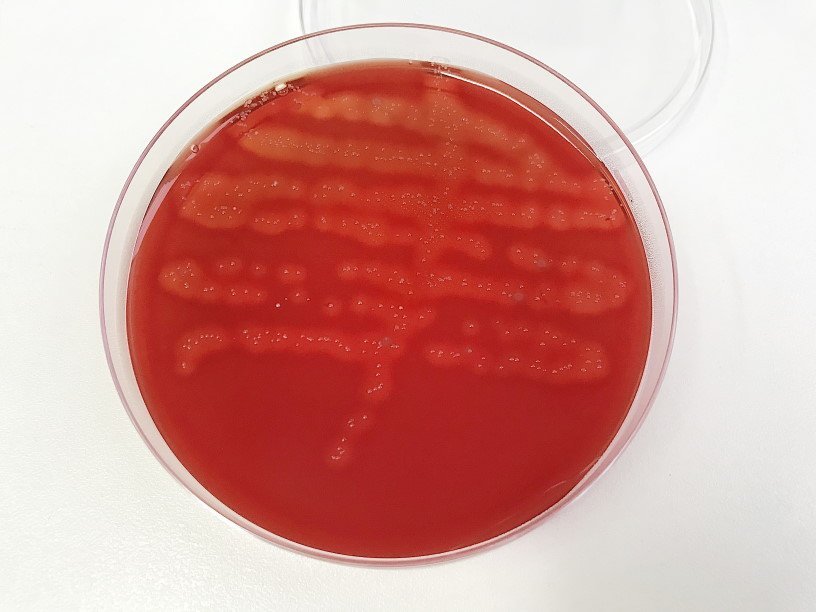

Екатерина Беленко: Промикробы: Самый близкий враг
Фото: Екатерина Беленко Человек человеку, конечно, волк. А микроб человеку кто? Основными формами взаимодействия микро- и макроорганизмов являются мутуализм, комменсализм и наш любимый паразитизм. Мутуализм — это взаимовыгодные отношения, например, нормальная микрофлора. Комменсализм — отношения, когда выгоду извлекает один партнер (микроб), не причиняя особого вреда другому. Тут мы делаем сноску и вспоминаем, что при любом типе взаимоотношений микроорганизм может проявить свои скрытые подлые патогенные свойства (комменсал-микроб становится условно-патогенным в обстоятельствах иммунодефицита хозяина, например). Паразитизм — крайняя форма антагонистического взаимодействия, когда микроорганизм питается за счет хозяина, т. е. извлекает выгоду, нанося при этом вред многоклеточному добродетелю.
⠀
Самая крайняя форма микробного паразитизма — внутриклеточный или облигатный. К облигатным (обязательным) внутриклеточным паразитам относят микроорганизмы, способные жить и размножаться только в клетке хозяина. В процессе перехода от свободноживущего к паразитическому типу жизнедеятельности микроорганизмы теряют ряд ферментных систем, необходимых для существования во внешней среде, но приобретают ряд свойств, обеспечивающих возможность паразитизма. Среди бактерий облигатный паразитизм характерен для хламидий и риккетсий.
⠀
Хламидии — грамотрицательные кокковидные неподвижные бактерии, спор и капсул не образуют. Это облигатные внутриклеточные паразиты, не способные самостоятельно синтезировать АТФ (думаю, эту молекулу все со школы помнят), то есть являются энергетическими паразитами. Они размножаются в вакуолях или в цитоплазме клеток человека, млекопитающих, птиц. Хламидии не растут на искусственных питательных средах, поэтому в лабораторных условиях их культивируют на куриных эмбрионах и культурах клеток человека или животных.
Патогенными для человека являются следующие представители рода Chlamydia:
Chlamydia pneumoniae — совершенно предсказуемо из названия, возбудитель бронхопневмонии у человека. Chlamydia trachomatis вызывает самые различные инфекционные заболевания, в зависимости от штамма возбудителя. Самая частая и известная зона поражения — урогенитальный тракт, а хроническое воспаление органов малого таза при урогенитальном хламидиозе может привести к бесплодию.
⠀
Риккетсии — грамотрицательные, аэробные бактерии, неподвижные, спор и капсул не образуют, отличаются плеоморфизмом. Это значит, что они меняют форму своего микротельца — чаще всего они имеют палочковидную или кокковидную форму, но иногда могут встречаться даже нитевидные клетки. Эти бактерии являются облигатными внутриклеточными паразитами, так как не способны синтезировать НАД (внимание, сейчас будет страшное полное название — никотинамидадениндинуклеотид). Для их культивирования в лабораторных условиях также используют куриные эмбрионы или культуры клеток млекопитающих. Риккетсии могут быть патогенны для млекопитающих и человека, вызывая риккетсиозы. Для большинства этих заболеваний характерно поражение кровеносных капилляров и кожных покровов, сопровождающееся появлением обильной сыпи, головные боли, лихорадочные состояния. Переносчиками риккетсий являются вши, блохи, клещи. Наиболее известными риккетсиями, патогенными для человека, являются представители родов Rickettsia, Coxiella и Ehrlichia.